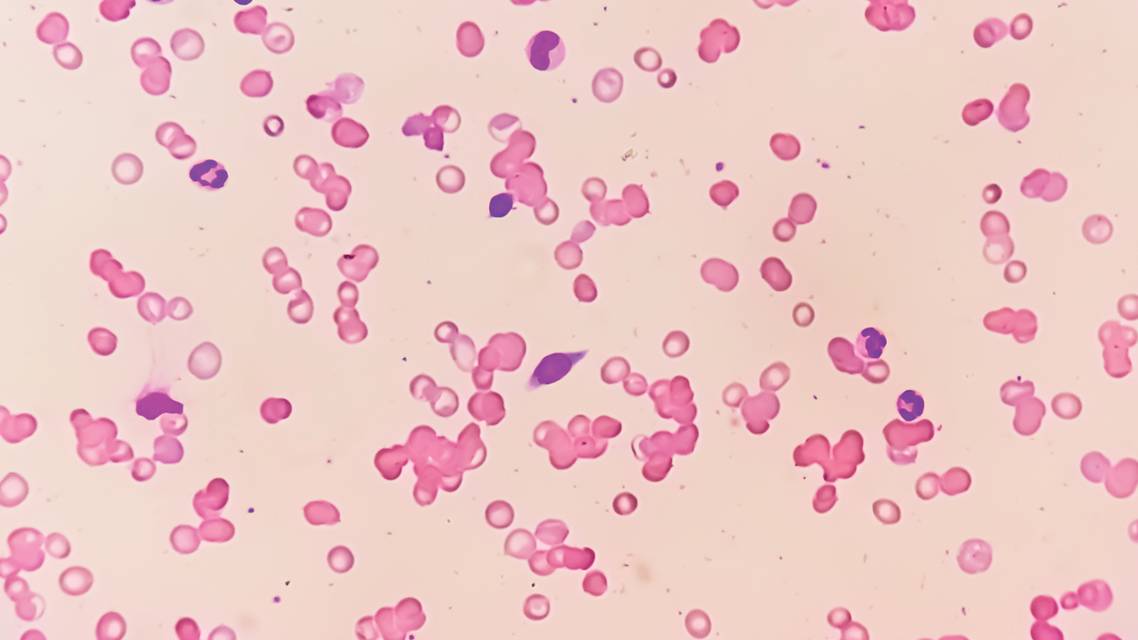
Retinal Imaging in Hematologic Disorders

Retinal Imaging in Hematologic Disorders
AT A GLANCE
- Retinal findings are often the initial indication of an underlying, relapsing, or worsening hematologic disorder, such as anemia, sickle cell disease, leukemia, lymphoma, and myeloma.
- The pathophysiology is not yet completely understood, but retinal ischemia, hypoxia, and changes in blood viscosity may contribute to the presence and severity of retinopathy in hematologic disorders.
- Multimodal imaging allows early identification of retinal findings that may be indicative of underlying conditions requiring immediate comprehensive medical evaluation and treatment.
Hematologic disorders are a diverse group of conditions that affect millions of Americans. Conditions often seen within this group include anemia, sickle cell disease (SCD), and hematologic malignancies such as leukemia, lymphoma, or myeloma. Hematologic disorders are increasing in prevalence.1 Anemia affects more than 3 million individuals in the United States and nearly 2 billion globally.2,3 SCD is one of the most prevalent hereditary disorders among individuals of Mediterranean or African ancestry and has increased globally by 41.4 %.4 Hematologic malignancies are among the most commonly occurring cancers.5
In most cases, retinal findings are the initial indication of an underlying, relapsing, or worsening hematologic disorder.6 Identifying these findings not only allows early detection and prompt diagnosis, but also timely intervention, thus preserving vision and potentially even saving lives. This article discusses the use of multimodal retinal imaging in the detection of hematologic disorders.
IMAGING RETINAL FINDINGS IN HEMATOLOGIC DISORDERS
Hematologic disorders can affect the retina in multiple ways, producing a wide range of retinal complications. Although the exact pathophysiology is not completely understood, retinal ischemia, hypoxia, and changes in blood viscosity may contribute to the presence and severity of retinopathy in hematologic disorders.7 Common retinal findings include cotton-wool spots, retinal hemorrhages, Roth spots (ie, white-centered hemorrhages), exudation, nonperfusion, neovascularization, and infiltration (see Common Retinal Findings in Hematologic Disorders). Multimodal retinal imaging is critical in detecting findings of hematologic disorders, specifically early and subclinical complications.
Common Retinal Findings in Hematologic Disorders
- Cotton-wool spots
- Exudation
- Retinal hemorrhages
- Microaneurysm
- Flame-shaped
- Roth spots
- Preretinal
- Intraretinal
- Subhyaloid
- Vitreous hemorrhage
- Nonperfusion and neovascularization
- Retinal vascular occlusions
- Retinal and choroidal infiltration
Anemia
Anemia may be caused by several factors, including nutritional deficiencies or inherited red blood cell disorders. Iron deficiency is the most prevalent cause of anemia, with a recent study finding that a large proportion of adults in the United States—nearly one in three—may have iron deficiency anemia.8,9 About a third of patients with anemia have some degree of retinopathy, including hemorrhages at all levels of the retina and choroid, hard exudates, and cotton-wool spots (Figure 1).10 The prevalence of such signs increases with severity of the condition or with concomitant thrombocytopenia, a disorder of low platelet count.8 Because anemia may also worsen conditions such as diabetic retinopathy or be a manifestation of other systemic diseases such as cancer, infection, or autoimmune disorders, it is always worth investigating the cause.

SCD
As the prevalence of SCD increases globally, the potential of sight-threatening sickle cell retinopathy increases. Retinal manifestations of SCD include sickle cell retinopathy, classified as either nonproliferative or proliferative, sickle cell maculopathy (SCM), and arterial and venous occlusive diseases (Figure 2). Sickle cell retinopathy has been reported to develop in 40% of individuals with SCD during the second decade of life.11

SCM is characterized by perifoveal thinning of the temporal macula on OCT due to ischemia. Areas of retinal thinning are associated with a reduction of vascular flow in both the superficial capillary plexuses and deep capillary plexuses, as well as an enlargement of the foveal avascular zone on OCT angiography.12 Studies have shown that SCM has been correlated to peripheral disease and may be a surrogate marker for peripheral retinopathy.13
Malignancy
Leukemic retinopathy is a common manifestation of leukemia and is found in both acute and chronic forms (Figure 3). Up to 50% of patients with leukemia may have retinal abnormalities, which is associated with poor prognosis.14 Leukemic retinopathy may arise from direct infiltration of cancerous cells or a consequence of leukemia-induced hematologic abnormalities (eg, dot-blot hemorrhages, flame hemorrhages, Roth spots), preretinal hemorrhages, and cotton-wool spots.15

Lymphomas are a diverse group of cancers of the lymphatic system that comprise 4% of cancers diagnosed annually.16 Hodgkin disease is the most common form of lymphoma; all other lymphomas are termed non-Hodgkin lymphoma. Detection of vitreoretinal lymphoma, characterized by diffuse choroidal infiltration or exudative retinal detachment, is critical in non-Hodgkin, diffuse, large B-cell lymphoma, as it indicates central nervous system involvement.17
Retinal complications are also a common finding in patients with multiple myeloma, a neoplastic plasma-cell disorder resulting from malignant plasma cells in the bone marrow. Of note, the presence of retinopathy in patients with multiple myeloma usually does not indicate a worse prognosis and can improve with systemic treatment.18
A GROWING CONCERN
Hematologic disorders are increasing in prevalence. Multimodal imaging allows early identification of retinal findings that may be indicative of underlying conditions requiring immediate comprehensive medical evaluation and treatment.
Ready to Claim Your Credits?
You have attempts to pass this post-test. Take your time and review carefully before submitting.
Good luck!